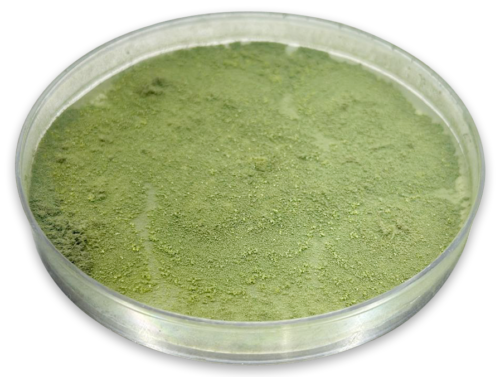

Institutional Collaboration and Scientific Engagement
Proteogenixx Lifescience Pvt. Ltd. is presently engaged in a structured and scientifically rigorous collaborative research program at BBB–RCB (Regional Centre for Biotechnology). This partnership is designed to integrate industrial research capabilities with advanced institutional infrastructure in order to develop robust, high-sensitivity analytical platforms of translational and regulatory significance. The collaboration reflects a strategic commitment to innovation-driven research aligned with national priorities in food safety and biotechnology.
Regulatory Compliance and RCGM Approval
Within this framework, Proteogenixx contributes its technical proficiency in recombinant protein engineering, immunochemical assay development, molecular biology methodologies, and analytical validation systems.
The project involves the controlled expression and purification of recombinant biomolecules, characterization of antigen–antibody interactions, and systematic optimization of enzyme-linked immunosorbent assay (ELISA) platforms.
Analytical standardization is undertaken to ensure reproducibility, precision, and sensitivity across diverse biological and food-derived matrices.

Scientific Focus: Aflatoxin Detection and Analytical Development
A principal objective of the project is the development and validation of sensitive immunodetection systems targeting aflatoxins, a class of structurally related mycotoxins predominantly produced by Aspergillus flavus and Aspergillus parasiticus. Among these compounds, Aflatoxin B1 is recognized as one of the most potent naturally occurring hepatocarcinogens and is therefore subject to stringent regulatory control worldwide.
Aflatoxin contamination is commonly associated with cereals, maize, groundnuts, oilseeds, spices, animal feed, and dairy products, the latter primarily through the metabolite Aflatoxin M1. The persistence and stability of these toxins under storage conditions underscore the necessity for highly sensitive and reliable analytical detection systems capable of meeting regulatory compliance standards established by national and international authorities.

